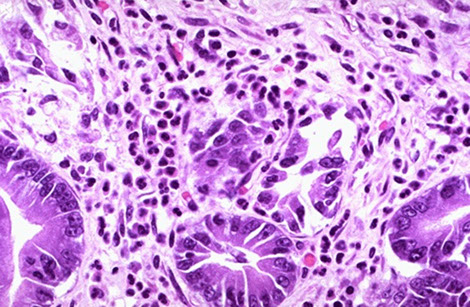
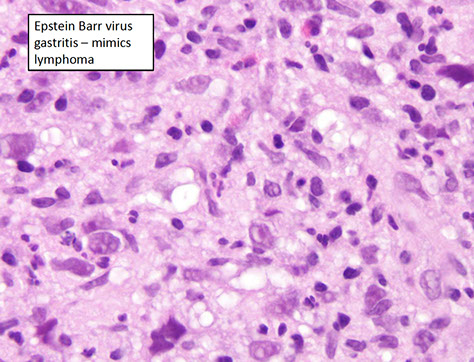
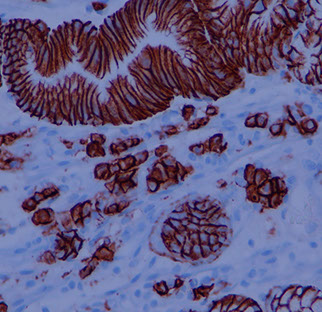
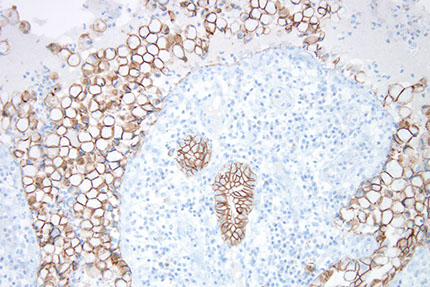

Stomach
Embryology, anatomy, histology
Stomach biopsy interpretation basics
Erosion vs ulcer?
Gastric Ulcer
Acute (erosive) gastritis
- Acute hemorrhagic gastritis
- Chemical gastritis / reactive gastropathy
Chronic (nonerosive) gastritis
- Type A: Autoimmune gastritis (AMAG)
- Type B: Bacterial (H pylori) gastritis
Amyloidosis
Menetrier's disease
Collagenous gastritis
Gastric Crohn disease
Granulomatous gastritis
Hyperplastic / Hypertrophic gastritis
Infectious gastritis (syphilis, CMV, EBV)
Russell body gastritis
Immunodeficiency gastritis (CVID and GVH)
Mucosal calcinosis
Proton pump inhibitor effects
Iatrogenic injury / Chemical injury
Phlegmonous gastritis
Gastric antral vascular ectasia
Portal gastropathy
Dieulafoy lesion
Gastritis cystica polyposa / profunda
Lymphocytic gastritis
Pyloric stenosis
Gastric fundic gland polyp
Inflammatory fibroid polyp
Hyperplastic polyp
Hamartomatous / syndromic polyp
Cronkhite-Canada polyp
Pancreatic acinar cell metaplasia / heterotopia
Gastric xanthoma
Intestinal / Gastric foveolar-type adenoma
Pyloric gland adenoma
Oxyntic gland polyp / adenoma
Mesenteric fibrosis
Zollinger-Ellison syndrome
Adenocarcinoma
GastroIntestinal Stromal Tumor (GIST)
Well-differentiated Neuroendocrine tumors (carcinoid tumors) and other neuroendocrine tumors
Gastric MALT lymphoma
Granular cell tumor
Neural tumors
Schwannoma
Glomus tumors
Synovial sarcoma
Plexiform fibromyxoma
Gastroblastoma
Mestasis
Stomach
Stomach embryology
Made of endoderm, the stomach starts as foregut dilation, and is fully developed by parturition.
Rugae/ mucosa of different zones (cardiac, fundus, body, antrum, and pylorus) appear grossly different, depending on distentiability.
- Areae gastricae - slight indentations in mucosa; grossly visible
Stomach Anatomy
Four parts: Cardia, fundus, body, and pylorus
- has lots of rugae if not distended
Cardia - opens from the esophagus, at level of T11
- lined c mucin-secreting foveolar cells forming small glands
Fundus - dilated superior portion; have chief cells (make pepsin)
- cardial notch bwt esophagus and fundus
Body (corpus) - largest part of stomach bwt fundus and pylorus
Pylorus / Antrum - goes from pyloric antrum to pyloric canal to pyloric sphincter
- lined c mucin-secreting foveolar cells forming small glands, also have endocrine cells (G cells) to stim luminal acid secretion by parietal cells in fundus and body
Most of vascular supply comes from aorta: right and left gastric arteries and right and left gastro-epiploic (gastro-omental) arteries anastamose along greater and lesser curvatures, respectively
- fundus gets blood from short and posterior arteries
Stomach Histology
Basically two types of epithelium in stomach:
1. Oxyntic type
- Has chief cells (blue chief [are more acidic]) and parietal cells (pink parietal, are basic because secrete acid)
- Have a thin foveolar region and thicker glandular region
2. Antral type
- Have thicker foveolar region, the foveolar region and glandular region sizes are ~50/50% of the epithelial thickness
- Secretes mucous and doesn't have chief and parietal cells
6 major cell types: (1) Mucous neck cells, (2) Parietal cells (oxyntic cells), (3) Chief cells (peptic cells), (4) Stem cells, (5) Enterochromaffin cells (gastroendocrine cells) (6) foveolar cells
(1) Mucous neck cells - oval nuclei c mucus in apical droplets
- different from goblet cells
(2) Parietal cells (oxyntic cells) - MC in upper part of body of gastric gland, separated by chief cells, have lots of mitochondria
- secrete hydrochloric acid and intrinsic factor (IF)
(3) Chief cells (peptic cells) - MC in lower part of gastric gland, apical portion has secretory granules c pepsinogen, stimulated by acetylcholine
- uncommon in antrum or pylorus
(4) Stem cells - adjacent to neck region, continuously renew gastric mucosa; can migrate anywhere in gland to replace necessary cells
(5) Enterochromaffin cells (gastroendocrine cells) - has apical nucleus and light cytoplasm; produce peptide hormones
- member of the Diffuse Neuroendocrine System (DNES)
(6) Foveolar cells - line entire stomach; secrete mucin, appear magenta to pink on PAS
- there is no "foveolar mucosa", just oxyntic (has chief cells) or antral-type (mucous-secreting)
- the duodenum can have "foveolar metaplasia"
Wall levels: 1) Mucosa, 2) Submucosa, 3) Muscularis propria, and the 4) Serosa
- (2)-(4) same throughout GI
Mucosa
- homogenous pattern throughout stomach, covered in mucus, and contains highly intertwined glands
4 gland parts: (1) Foveola (gastric pit) (2) isthmus (3) neck (4) body
(1) Foveolae (gastric pits): microscopic invaginations that receive glandular secretions at their bases, lined by foveolar (mucous) cells
-- Lamina propria separates foveolae / glands
-- entry (cardiac) and exit (pylorus) tissue has lots of mucus glands, and has wider foveolae (villous appearance) and deeper foveolae (~50% of cariac/pyloric mucosal thickness) and lamina propria thick
- between mucosal regions of the cardia and pylorus in the body and fundus, glands secrete more pepsin and acid
(2) Isthmus - in the body and fundus made of mostly parietal cells (oxyntic cells), but also has mucous neck cells
- endocrine cells in the deep part of isthmus towards neck / base
(3) Neck - narrow portion of gland underneath fovealar region;
- has mucous cells (MC cell type), parietal cells and stem cells
(4) Body / base - majority of length of gland
- parietal cells MC in upper portion, are separated by chief cells
- chief cells MC in lower (end) portion, and has apical granules with pepsinogen
Lamina propria should not have too many lymph and / or plasmas; neutrophils should not be in mucosal epithelium or lamina propria, though eos are a normal part of the lamina propria
- these inflammatory components more prominent in intestines
Difference of stomach histology by region:
Cardiac and antral type versus fundus and body type
- cardiac and antrum protect esophagus and (from) duodenum (respectively); is made mostly of mucous cells, though the antrum also has G (gastrin-makin) cells not seen in cardia (or in body or fundus for that matter)
-- in atrophic gastritis can see "antralized" body and / or fundus with G cells
- Fundus and body make the acids / enzymes
Submucosa
Loose CT and elastic fibers btw. muscularis mucosae/ muscularis propria;
- contains Meissner's plexus
- Muscularis mucosae: outer longitudinal and inner circular
Muscularis propria
Outer longitudinal (continuous w/ esophagus muscle), then circular, finally inner oblique
- Circular layer bulks up to for pylorus
Stomach biopsy interpretation basics
Note clinical info, such as age and gender (ie AMA more common in elderly females)
- signet-ring adenoca is sneaky, subtle, only hint from clinical info may be some concern such that stomach inflates or some other little thing, prompting a more careful review
- carefully review all areas with fibrosis
- crushed oxyntic glands with lots of mucous neck cells can look like signet-ring adenoca (but mucous cells should be within glands)
- gastric xanthoma, acute hemorrhagic gastritis and pill gastritis can look concerning too




Gastric oxyntic mucosa c short foveolae and tightly packed glands

Gastric oxyntic mucosa c purple chief cells and lighter pinker parietal cells



Gastric ulcers
Breach into the submucosal layer or deeper (vs erosions, which are only into mucosal epithelium)
Sx: pain greater with meals --> weight loss
- pain not relieved by antacids
Usually in older pts; and in lesser curvature of stomach [?]
H pylori infx in 70% (dx w/ urea breath test); also caused by chronic NSAID use
Dec mucosal protection against gastric acid
Tx: triple therapy of PPI, clarithromycin, and either amoxicillin or metronidozole causes eradication in ~90% of cases
Acute gastritis

Acute gastritis with neutrophil infiltration
Acute (erosive) gastritis
Aka Reactive / Chemical gastropathy
- hypertrophic gastropathies refer to Menetrier and ZE syndrome
Disruption of mucosal barrier causes inflammation (gastric lumen pH about 1, which can cause damage without protection (ie mucin from foveolar cells, bicarb from surface epithelial cells)
Causes: stress (esp severe trauma), NSAIDS (dec PGE2 --> dec mucosal protection) [think of pts w/ RA], EtOH, uremia, burns (Curling's ulcer --> dec plasma volume --> sloughing of gastric mucosa), brain injury (Cushings ulcer --> inc vagal stim --> inc ACh --> inc H+ prod), dec O2 delivery may cause at high altitudes
*** burned by the CURLING iron; always CUSHION the brain***
Micro: Foveolar hyperplasia/ edema/ hyperemia, fresh focal hemorrhage, focal necrosis of surface of foveolar cells
- vasc congestion
- minimal chronic inflam
- fibromuscular hyperplasia in lamina propria
Acute infectious nonbacterial gastroenteritis: (Norwalk virus) usually no lesion detectable
Pitfall erosive gastropathy note that the reparative
glands respect the muscularis mucosae border. [1]

Acute hemorrhagic gastritis
Acute, life-threatening (55% die), usually in context of chronic gastritis. Multiple causes (EtOH [MC], phosphasoda bowel prep, NSAIDS, CMV)
- multiple areas of hemorrhage throughout mucosa, may not be bx'd to avoid further exacerbation
On endoscopy, see erythema or intramucosal hemorrhage, from petechiae to large ecchymoses
Chemical gastritis / reactive gastropathy
MC in antrum, usually 2/2 bile reflux (pts usually being evaluated for GERD), also assoc c NSAIDs, EtOH use, anticonvulsants
- "stump cancers" may be seen in pts c antrum removed (antrectomy) in which bile can freely enter the stomach
Micro: foveolar hyperplasia, lamina propria edema, muscular stranding, vascular extasia with little acute and chronic inflam,
- can have similar micro picture as Gastric Antral Vascular Ectasia (GAVE, aka "watermelon stomach"), which has antral linear erythema on endoscopy and pt has hx of iron-deficiency anemia

Reactive / chemical gastropathy
Chronic (nonerosive) gastritis
MCC = H pylori (usually antral gastritis, assoc c poverty), then autoimmune; sx are less severe but more persistent
- can produce gastrin locally which can cause duodenal peptic ulcers, but serum gastrin usually normal
- multifocal atrophic gastritis assoc c patchy mucosal atrophy, reduced parietal cell mass c loss of acid secretion, inc risk AC
- H pylori virulence linked to flagella, urease, adhesins and toxins (CagA implicated in risk of multifocal gastritis and AC)
- usually erythematous or nodular on endoscopy
Main features: 1) Infiltration of lamina propria w/ inflammatory cells
- chronic superficial gastritis: limited to foveolar region, little to no atrophy
- can have prominent subepithelial plasma cells and lymph aggs
- neuts variable, can form pit abscesses in lumens
2) Atrophy of glandular epithelium
- if get (2) termed chronic atrophic gastritis, and can add degrees of severity (mild, moderate, severe) based on level of involvement
-- need to correctly orient tissue in order to grade
- Gastric atrophy: thinning of mucosa (glands spread out, lamina propria inc) in absence of superficial inflame changes
-- probably the end stage of chronic atrophic gastritis
- oxyntic mucosa can look antral
Chronic atrophic gastritis usually accompanies gastric carcinomas and ulcers.
Early stages of inflame. show cytoplasmic mucin loss, and enlarged nuclei w/ prominent nucleoli in the glands.
- may see inc. mitoses at foveolar bases, indicated inc cell turnover
Metaplasia - caused by gastritis (esp. H. pylori)
Chronic gastritis in gastric body caused by H pylori

Chronic gastritis

Intestinal metaplasia (IM)
- surface and pit epithelium change to resemble rest of GI
-- (+) hepatocyte antigen (Hep-Par-1) and guanylyl cyclase, and T (Thomas-Friedenreich) antigen
Type I (complete): looks like small bowel (goblet cells, absorptive cells (enterocytes) w/ brush border, endocrine cells)
-- (+) - sialomucin in columnar cells (+MUC2 and absent MUC1, MUC5AC, MUC6), w/ small amt of sulfo-/ neutral mucins
-- usually no H pylori
-- if very advanced, can get crypts and villi w/ Paneth cells
Type II (incomplete): resembles colon; absorptive (enterocytes) not seen, but do see goblet cells. Foveolae should look the same.
- sulfomucins (type IIB)/ neutral (IIA) mucins predomionate, with small amounts of sialomucins also produced
-- thus all of the mucin stains are strongly positive (MUC1/2/5AC/6)
Pyloric Metaplasia (PM) of fundic mucosa
Special acid/ enzyme secreting glands replaced by mucin glands
- pylorofundic junction moves proximally towards cardiac region
- (+) for H pylori
-- seeing H pylori in epithelium probably means severe damage
Inactive Chronic Gastritis
Usually 2/2 H pylori
- micro: at low power has only minor inflam component in lamina propria
Metaplastic atophic gastritis
- 2 flavors: Autoimmune (ie AMAG) and Environmental gastritis
Autoimmune Metaplastic Atrophic Gastritis (AMAG)
- formerly type A (Autoimmune) gastritis , loss of parietal cells (loss of acid secretion and IF), 2/2 CD4+ T cell attack from auto-abs
Lymphs and macros seen in fundus/ body.
- <10% of chronic gastritis, MC in females
Autoimmune disorders w/ Ab's to parietal cells (proton [H+/K+-ATPase] pump) in gastric body, pernicious Anemia (vit B12 def from lack of intrinsic factor 2/2 no parietal cells), Achlorhydria
- dec parietal cells -> dec acid -> inc gastrin -> stim ECL-cell hyperplasia (nodular or linear)
-- Schilling test (+)
- high serum gastrin, but low acid production (no ulceration)
*** AB pairing: pernicious Anemia affects gastric Body ***
Mech: CD4+ T cells attack parietal cell's and the H+/K+/ATPase
Antrum spared (bc does not have parietal cells), neuroendocrine (ECL cell) hyperplasia (leads to inc risk of carcinoid)
- loss of parietal cells, and leads to hyperplastic polyps
May lead to Adenoca or multiple carcinoid tumors
- also assoc c Graves dz, thyroiditis and DM
Autoimmune MAG (AMAG) Clinical Correlations [1]
• Achlorhydria or marked hypochlorhydria
• B 12 malabsorption
• Serum gastrin high levels
• Gastric cancer: risk increased
• Gastric ulcer: not a problem (no acid!)
Evolving Autoimmune Gastritis [1]
• Incomplete parietal cells loss
• Areas of apoptotic damage of parietal cells
• Pockets of pyloric and pancreatic metaplasia
• ECL cell hyperplasia present
• Sometimes H. pylori present; if so, some data suggest that eradication can forestall parietal cell loss
Micro: body shows loss of oxyntic cells and deep glands that look like antral mucosa ("antralized" body), but gastrin stain will be negative (proving that it is from the body, and not the antrum)
- pancreatic acinar cell metaplasia can be seen
-Body (ONLY!)) -->DIFFUSE METAPLASIA; mucosa thin
--> Loss of oxyntic glands (“atrophy”)
- Antrum NO METAPLASIA; hyperplasia
- Endocrine --> G cell hyperplasia; ECL cell hyperplasia
SAMPLE REPORT:
• Gastric body (biopsy): Autoimmune gastritis/pernicious
anemia pattern
• Note; These patients are prone to both iron deficiency
anemia and pernicious anemia (the high gastric pH
interferes with iron absorption) as well as various
epithelial neoplasms. Correlation with serum gastrin
and studies of vitamin B12 levels may be of interest.
IHC: (+) CHR (present normally in ECL and antral G cells, but are abundant in this dz), gastrin (highlights G cell hyperplasia in antrum
- neg: should be neg in body (even if "antralized")

Intestinal metaplasia in gastric pits in autoimmune gastritis


Pancreatic metaplasia [1]




Peptic Ulcer Disease (PUD)
chronic mucosal ulceration in duodenum or stomach, caused by H pylori, NSAIDs or cigarettes; ulcers usually solitary
- MC in gastric antrum or duodenum, caused by H pylori, c inc gastric acid secretion and dec duodenal bicarb secretion
- if seen in fundus or body, assoc c mucosal atophy
- classic peptic ulcer is round sharply punched out defect (heaped up margins more characteristic of cancers), have smooth bases
- perforation is an emergency
- pt usually gets pain 1 to several hours after ingestion, pain relieved c food and alkali; can present c iron def anemia
Micro: can see granulation tissue beneath ulcer base
Px: rarely turned malig
Autoimmune enteropathy (AIE)
Rare cause of intractable diarrhea assoc c circulating gut autoabs, mostly affecting kiddos; must distinguish from refractory sprue
- FOXP3 mulecule governs maturation of Treg cellsc CD4+ and CD25+ molecules
- Immune dysfunction, Polyendocrinopathy, Enteropathy, and X-linked inheritance (IPEX) assoc c FOXP3 mutations on X-chromosome, and are probably responsible for most cases of AIE
3 diagnostic criteria:
1) severe villous atrophy not responding to dietary restriction
2) circulating gut autoabs and/or assoc autoimmune conditions
3) lack of severe immunodeficiency
Micro: similar changes as AMAG (glandular atrophy c lots of lympho-plasmacytes +/- intestinal metaplasia), but, unlike AMAG, antrum is equally affected and no ECL cell hyperplasia
Figure 1: Gastric mucosal biopsies from children with autoimmune enteropathy often showed features of (a) chronic gastritis with increased lamina propria lymphoplasmacytic inflammation forming a superficial band within the mucous neck region. (b) In some cases, prominent intraepithelial lymphocytosis was identified within the surface, foveolar epithelium consistent with lymphocytic gastritis. (c) Concurrent autoimmune-related disorders were a common finding in patients with autoimmune enteropathy. Gastric biopsies taken from the fundus of case 14 demonstrated the features of autoimmune atrophic gastritis with partial parietal cell loss and superficial intestinal metaplasia. (d) In a subset of patients, multiple apoptotic bodies (arrows) were identified within the deep glandular mucosa.

Atrophic autoimmune Pangastritis
Micro: mod-to-marked bottom-heavy lymphoplasmacytic and neutrophilic lamina propria infiltrates persisting into glandular atrophy, involving both antrum and body, no ECL hyperplasia or H pylori infx, and with evidence of systemic autoimmune dz
- more similar to AIE than AMAG
- may inc risk of gastric ca
- must correlate c clinical info
tx: immunosuppressants
Environmental Metaplastic Atrophic Gastritis
- H pylori probably most important cause, but also assoc c smoked foods, very salty diet, lack of green veggies and fruit
- has also been called type B gastritis or multifocal atrophic gastritis
-most prominent in antrum, first appearing at the incisura angularis (transitional zone bwt antrum and body), body relatively spared (though can show pseudopyloric intestinal metaplasia)
- have enough parietal cells to not get pernicious anemia
Clostridium ventriculi
Previously known as Sarcina ventriculi
- may be associated with gastric outlet obstruction such as in patients with diabetes
• Gram positive, anaerobic, sugar fermenting bacterium, S. ventriculi was first observed in the human stomach in 1842 by Goodsir . Readily found in soil and is known to cause a similar type of gastric injury in animals.
• Delayed gastric emptying and carbohydrate stasis in association with acidic gastric juices may provide an ideal culture medium
• Studied patients all had underlying delayed gastric emptying (one
had a bezoar) from diabetic neuropathy, narcotic use, and pyloric
stenosis secondary to malignancy
• The organism may simply colonize pre existing lesions but there
are too few cases to draw firm conclusions as to whether the
organism is truly a pathogen.
• Packets of 4, 8 or more cells with characteristic flattening
Clostridium ventriculi - assoc c gastric outlet obstruction

Helicobacter gastritis
- formerly Type B: Bacterial chronic gastritis
MC type. Begins in Antrum and moves proximally. Caused by H pylori. Inc risk of MALT lymphomas and adenoca
Cause hyperplastic / inflammatory polyps
- can identify H pylori w/ Giemsa, Warthin-Starry, proteinase K (?), Steiner silver stains, or H pylori IHC
- endoscopically can see mucosal mosaic appearance with or without hyperemia
Micro - in type B, see plasma cell and lymphocytic infiltrate in lamina propria c mucosal atrophy and gland loss
- neutros [active gastritis], monos [chronic], lymph aggs / secondary follicles, erosions, atrophy, foveolar hyperplasia, metaplasia all can be found c H. pylori infx
- may have lymph aggs or primary follicles in normal stomach, but secondary lymph follicles with germinal center should tip you off to ag exposure and thus H pylori
H. heilmannii cross-reacts on IHC, but is slightly more coiled and more rare, and causes a less severe gastritis in antrum
- H heilmannii in up to 4% of bx, and is very common infx in cats, dogs, and pigs (may suspect zoonotic transmission if in humans)
- can inc risk of MALT lymphoma and gastric cancer
- same tx as H pylori (IHC can cross-react from H pylori)
IHC may or may not be necessary, but can be esp useful in eval of gastric Crohn dz, esp if patchy and if doesn't have granulomas or if organisms not readily seen on HE
- inc levels of pepsinogen assoc c H pylori, while dec pepsinogen assoc c atrophic gastritis
Tx: triple therapy of PPI, clarithromycin, and either amoxicillin or metronidozole causes eradication in ~90% of cases
H heilmannii, suspect zoonotic transmission, may also cause MALToma / cancer


Amyloidosis
endoscopy non specific; nonspecific presentation, perhaps malabsorption
- similar histology as anywhere else in body, usually see friable mucosa assoc c hemorrhage and can be highlighted c Congo red
- should try to characterize the type of amyloid
Menetrier's disease
- see Foveolar hyperplasia in hypertrophic gastritis
Gastric hypertrophy w/ protein loss, excessive TGF-a production
- Inc mucous secretion --> protein loss
- clustered incidence in middle-aged men (30-60 yo)
-- Childhood form assoc w/ CMV infection, H pylori in adults
*** hypo-CPG: Chlorine / Protein / Gastrin ***
Precancerous lesion (inc risk gastric cancer)
- Rugae so hypertrophied they look like brain gyri
Micro: parietal cell atrophy, inc mucous cells (lots of mucous production), mucosal cysts, foveolar hyperplasia, glandular atrophy, edematous but uninflamed lamina propria usually limited to body and fundus
IPX (?): TGF-alpha
Tx: supportive
Menetrier disease


Collagenous gastritis
Assoc c collagenous and celiac sprue, lymphocytic and collagenous colitis, lymphocytic gastritis and other autoimmune dz
- anemia is common presentation in kiddos, whereas in adults see nausea, vomits, diarrhea, abd pain weight loss; F>M, no H pylori assoc
Micro: prominent subepithelial colagen, intraepithelial lymphs and surface epithelial damage c flattened and detached epithelium
- can highlight c trichrome stain
• Associated with various autoimmune diseases in both children
and adults
• We have seen it associated with medications (e.g. Benicar/Olmesartan)
• Early studies proposed 2 clinicopathologic subtypes:
• •(1) children (18 y of age or younger) presenting with severe anemia, nodular gastric mucosa, and isolated gastric disease; and
• •(2) adults with chronic watery diarrhea that is associated with diffuse collagenous involvement of the gastrointestinal tract.

Collagenous gastritis
Collagenous gastritis - trichrome [1]

Gastric Crohn disease
Micro: "focally enhanced gastritis" c small inflamed foci separated by normal mucosa; antrum > body; inc lymph, histiocytes and granulocytes; granulomas not that common
Granulomatous gastritis
- cause by Crohns in ~1/2 or H pylori, but usually unexplained and is of little clinical significance
- usually a descriptive dx is sufficient after r/o Crohns, sarcoidosis (usually non-necrotic granuloma), AC, or infection

Granulomatous gastritis
Hyperplastic / Hypertrophic gastritis
- seen as "giant / thickened folds" or "hypertrophic gastritis" by endoscopist, must differentiate foveolar from oxyntic gland hyperplasia
Foveolar hyperplasia
Menetrier disease: rare, M>F, chronic c unfavorable px; combo of hypertrophic gastric folds, oxyntic gland loss (thus achlorhydria) and protein loss (causing peripheral edema)
- Menetrier disease is just the clinical impression and does not get at the cause
- the mucin in massive diffuse foveolar hyperplasia has different profile from mucin normal stomachs, though on bx appears no different from hyperplastic polyp or a polyp seen in Cronkhite-Canada syndrome and hyperplastic foveolar epithelium arranged in disorderly fashion c loss of oxyntic mucosa in body or fundus
Oxyntic gland hyperplasia
Results from hypergastrinemia in pts c normal parietal cells
- if gastric mucosa intact, hypergastrinemia can results from gastrinoma (gastrin-making neoplasm) as part of Zollinger-Ellison syndrome
- parietal cells insinuated in epithelium at surface bwt residual foveolar cells (rather than nested down deeper in mucosa)
Infectious gastritis (syphilis, CMV, EBV)
- eos may be prominent, but not usually counted
Syphilis
- has a variable appearance, having lots of mixed inflam (similar to autoimmune pangastritis) c gastric gland damage; should do direct IF or immunolabeling if suspected


CMV
not uncommon in inpts, may be mistaken for lymphoma
EBV
- can appear similar to large cell lymphoma in same way that infectious mono simulates leukemia
EBV gastritis - mimics lymphoma [1]
Russell body gastritis
Incidental finding that is rare, poorly understood inflam c dense mucosal plasma cells c intracytoplasmic eosinophilic globules made of IGs (Russell bodies) that push the nucleus aside, c chronic inflam infiltrate
- pt presents c epigastric pain, usually a swelling or nodule on EGD, but can mimic malignancy
- usually assoc c H pylori (can resolve after H pylori tx), but also MGUS or EBV-assoc gastric ca
- may be mistaken for signet ring ca or MALT lymphoma (but Russell body gastritis does not have nuclear atypia and stains for CD138, CD79a and not keratins)
-- Russell bodies have been seen in MALT lymphoma and signet ring ca, and may occur concurrently with those 2, so important to r/o malignancy carefully
Russell body gastritis http://www.pathologyoutlines.com/caseofweek/case410.htm
CD138

Crystal storing histiocytosis
The flip side of Russell body gastritis
OFTEN associated with lymphomas
• Gastric cases arise in older adults
• Nodular on endoscopy
• Lamina propria expansion and distortion
• Associated with lymphomas
• Usually Kappa restricted based on limited data.
Crystal storing histiocytosis


“Signet cell change” in ischemic columnar mucosa
- cells lose their cohesion and slough into the
lumen whilst “rounding up” [1]
- pitfall for signet ring cell carcinoma
IHC: maintains E-cadherin expression
Pitfall --“signet cell change” in ischemic columnar mucosa; cells retain E- Cadherin expression
Signet cell change in ischemic mucosa [1]

Immunodeficiency gastritis (CVID and GVHD)
CVID
Nonspecific findings (as in esophagus), usually having lack of plasma cells and prominent lymphs in lamina propria and inc apoptotic bodies, and granulomata
GVHD
same as anywhere else in GI, c epithelial apoptosis and ulcers / erosions; may grade from mild to severe, compare c prev bxs and look for CMV
Mucosal calcinosis
Incidental finding (?) most likely caused by metastatic calcium deposits in pts c calcium metabolism disorders or taking antacids, which can manifest as renal failure; can be fatal in heart
- may also be assoc c atrophic gastritis, hypervitaminosis A, organ transplants, gastric ca, uremia, citrate in blood products, sucralfate or isoretinoin; may be reversible
Gastric mucosal calcinosis

Proton pump inhibitor effects
Reduced acid secretion in gastric parietal cells; changes can also be seen in pts not taking PPIs
- micro: parietal cells are hyperplastic c granular / vacuolated cytoplasm c apical snouts
PPI effects [1]


Histology slide of the antral-type gastric mucosa with slight atrophy (A), characterized by a reduction in the number of gland bodies in PPI user. (B) Fundic glands of a proton-pump user. A polyp of the fundic glands can be observed in panoramic view, highlighting the dilation of the crypts. (C) Magnification of the fundic gland polyp, showing the dilated crypt covered by fundic-type mucosa. (D) Numerous spiraled bacteria (black) are present on the surface of the epithelium and in the interior of the crypt in PPI user. (A and C - Hematoxylin-eosin, 400×; B - Hematoxylin-eosin, 100×, D - Wartin-Starry, 400×).
Iatrogenic injury / Chemical injury
Iron
Relatively common; usually in concert c some other dz process
- can have iron thrombi; has similar appearance as iron esophagitis
- may have severe changes that mimics carcinoma
- systemic iron overload (siderosis) is more rare and may cause changes in deep gastric glands
Iron pill gastritis with severe reactive epithelial changes [1]

gastric siderosis [1]

Gastric siderosis, iron stain [1]

Kayexalate
Can be assoc c gastric erosions / ulceration; since it is now suspended in hypertonic soln, can cause necrotic bowel
- may see kayexalate crystal formation, that look like fish scales
Kayexalate

Renvela

Colchicine / Taxol
May cause multiorgan failure; must mention in the report
- micro: metaphase mits (expanded prolif zone c Ki67), epithelial pseudostratification, loss of nuclear polarity, lots of crypt apoptotic bodies
- however, these changes can be seen in asx pts up to 4 days after beginning rx
Colchicine toxicity

Lanthanum carbonate (aka Fosrenol)
Fosrenol

Mycophenolate
Immunosuppresant used in organ transplants that inhibits de novo purine synth
- see prominent apoptosis in deep glands
Corrosive injury
Usually accidental injury by kids or suicide attempts by adults
- bx usually not taken at time of injury, but looks like hemorrhagic gastritis
Lifting agents
Cause multinucleated giant cell reaction
- trade names: Eleview and Orise
Pezhouh MK, Burgart LJ, Chiu K, Cohen DA, Hutchings DA, Sanderson SO, Shirazi M, Stanich PP, VandenBussche CJ, Voltaggio L, Willhoit ED, Xue Y, Arnold CA. Characterization of Novel Injectable Lifting Agents Used in Colonic Polyp Removal: An Emerging Amyloid Mimic. Am J Surg Pathol. 2020 Jun;44(6):793 798. PMID: 31934919.
Lifting agent gastritis

Radiation gastropathy
Can look like adenocarcinoma
Arnold CA, Pezhouh MK, Lam Himlin D, Pittman ME, VandenBussche C, Voltaggio L. 90Y TheraSpheres: The New Look of Yttrium 90. Am J Surg Pathol. 2019 May;43(5):688 694. PMID: 30720534.
Yttrium beads

Radiation gastropathy associated with yttrium [1]

Phlegmonous gastritis
Rare, suppurative inflam analogous to necrotizing fasciitis of soft tissue; presents c pain, nausea, foul vomit, hematemesis; high mortality rate (2/3 die)
- gastric wall thickening c hypodense areas on CT
- endoscopy shows thickened folds, ulcers, mass effects, surface necrosis
- caused by bugs (Strep, Staph, Enterococcus, E coli; can be seen on gram stain) usually in pts c HIV / immunodeficiency, after endoscopic mucosal resection c contaminated endoscope, after large EtOH ingestion
- may see emphysematous gastritis if caused by gas-forming bugs (Proteus, Clostridium, or Sarcina ventriculi)
Micro: acute inflam, necrotic mucosa / submucosa
Tx: abx or gastrectomy
Acute Phlegmonous Gastritis

Gastric antral vascular ectasia (GAVE)
- aka watermelon stomach (endoscopic appearance of longitudinal folds c visible red vessels radiating from pylorus in distribution resembling watermelon rind)
- ~50 yo F presents c iron def, secondary to chronic gastric bleeding, usually old women c hypochlorhydria, chronic liver dz, CREST syndrome or lymphoma
Micro: features reflecting mucosal prolapse component: foveolar hyperplasia, dilated mucosal capillaries, focal fibrin thrombi, fibromuscular hypertrophy
- IHC: CD61 may highlight thrombi (highlights platelet glycoprotein IIIa)
Tx: mucosal ablation (since pts have uncontrolled blood loss) endoscopically, and if that fails, need aggressive surgery
Gastric antral vascular ectasia (GAVE)

GAVE with a fibrin thrombus (off center to the right)

Portal gastropathy
- main differential consideration c watermelon stomach, can also cause GI bleeding, but not treated by endoscopic ablation, but instead tx tries to dec portal hypertension
- endoscopically this has a mosaic or "snakeskin" appearance
- assoc c liver dz causing portal HTN
Micro: no fibrin thrombi
IHC: CD31 shows inc lamina propria vessels and vessels larger than normal antral lamina propria vessels (also seen in GAVE)
Dieulafoy lesion
aka exulceratio simplex, caliber-persistent artery, gastric atherosclerotic aneurysm
Submucosal artery not branching properly, causing enlarged artery diameter
- uncommon cause of recurrent, usually massive potentially life-threatening bleed, cause 1/50 gi bleeds, usually older adults (6th decade), M>F, usually have comorbid conditions (HTN or ischemic heart dz), pt usually presents c hematemesis and melena, causing severe anemia requiring pRBC transfusions
- most can be found endoscopically, but angiography or repeat endoscopy may be needed if not found on initial endoscopy
- usually seen within 6 cm of the GE junction on lesser curvature (1/3 are extragastric in sm bowel, colon or rectum)
- usually not bx'd, but on autopsy resection see large vessel in upper submucosa that extends through mucosa
Tx: endoscopic methods (electrocoagulation, sclerotherapy, heat), up to gastrotomies
Dieulafoy lesion, bleeding like a horse https://www.youtube.com/watch?v=tzJQDen1nug

Gastritis cystica polyposa / profunda
uncommon, usually at gastroenterostomy stomas; a form of mucosal prolapse, c multiple polyps forming a circular ring, c thickened mucosal layer and lots of submucosal microcysts
Micro: elongated pits c serration, hyperplasia, custic dilation of pyloric glands that herniate into submucosa c regenerative surface epithelial change and fundic gland loss
- disorganized strands of muscularis mucosa in irregular bundles
Gastritis cystica profunda https://openi.nlm.nih.gov/detailedresult.php?img=PMC2893317_kjr-11-457-g009&req=4


Lymphocytic gastritis
is a pattern of inflam, not a specific dx, uncommonly seen in chronic gastritis c lots of lymphs in foveolar / surface epithelium
- assoc c celiac dz, H pylori gastritis, varioliform gastritis (gastropathy c enlarged folds, nodules and erosions on endoscopy)
- usually greater in antrum than body, no need to count lymph, just an overall gestalt impression of lymph prominence
- should do duodenal bx or serology to check for celiac dz
- pt may benefit from abx tx for H pylori
Lymphocytic gastritis [1]

Pyloric stenosis
3-5M:1F; in 1 in 300 to 1 in 900 live births; high concordance in monozygotic twins (assoc c 200x inc risk if 1 of the twins affected)
- inc risk c Turner syndrome and trisomy 18
- has also been linked to erythromycin and azythromyic either orally or by mother's milk in 1st 2 wks of life
- presents in 3-6th wk of like as projectile non-bilious vomiting and freq demands for re-feeding
- can be aqd as an adult from antral gastritis or peptic ulcers or from carcinoma of the distal stomach or pancreas
Abd exam reveals 1-2 cm firm "olive" in epigastrium
- comes from hyperplasia of the pyloric muscularis propria, obstructing the outflow of gastric tract
Tx: Myotomy (surgical incision)
Gastric fundic gland polyp


Gastric Fundic Gland Polyp (FGP)
Assoc c PPI use, ZE syndrome, MUTYH syndrome (?), and FAP, not assoc c malignancy, even if dysplasia found
Found in fundus and body (not antrum), MC sporadic than syndromic
- some drugs dec acid prod, causing inc gastrin secretion and oxyntix gland growth
- fairly common,
Micro: Microcysts lined by flattened chief and parietal cells
Genes: sporadic fundic gland polyps can have activating mutations of the CTNNB1 gene, while FAP-assoc fundic gland polyps have APC gene mutations
Px: nothing to worry if sporadic in pts taking PPIs, can start to worry if seen in FAP pts (which can lead to carcinoma in larger polyps)
Inflammatory fibroid polyp


Inflammatory Fibroid Polyp
B9 neoplasm, in adults, solitary, mesenchymal pseudoneoplasm seen throughout GI but esp in submucosa of gastric antrum, myxoid fibrous tumor whorled around BVs, has plasma cells and eos
- up to 1/25 of gastric polyps
- grossly are smooth submucosal lesions that can be pedunculated or sessile c surface ulceration / erosion in 1/3
- well-circumscribed, but not encapsultaed
Micro: very pale on low magnification, uniform spindly cells, perivascular onion-skinning around prominent, abundant vessels, myxoid background c eos
- mits infrequent
IHC: (+) CD34/ 35 (dendritic cells, spindled fibroblast-like cells), BCL2, SMA (+/-), fascin (may have dendritic cell diff), variable actin, calponin
- negative C-KIT (CD117), S100, ALK
Genes: PDGFRA mutations (similar to GISTs)
DDx: GIST (comes from the plexus, between the 2 layers of the muscularis propria)
Tx: excision; seldom recur
- can be managed with Gleevec (similar to GISTs)
Px: b9

Hyperplastic polyp
One of the MC gastric polyps, can be up to several centimeters
- may be 2/2 exaggerated response to mucosal injury; with histo features overlapping c Menetrier dz, Cronkhite-Canada syndrome, and hamartomatous polyps
- most develop in background of chronic gastritis
Micro: elongated, dilated foveolae lined c mature gastric mucin cells in edematous inflamed stroma; can have marked reactive changes
- 1/7 can have intestinal metaplasia and up to 1/5 have been reported to have dysplasia (may be closer to 1/25); rarely have AC
- may want to see areas surrounding areas of larger hyperplastic polyps, which are usually atrohpic or c inc inflam
- G cells of the antrum secrete gastrin which stimulate the parietal cells of the body (thus a bx of the body should not contain any cells that stain with gastrin markers; and the presence of lots of cells that stain for ECL are usually present in autoimmune gastritis)
Px: Some HPs may have epithelial dysplasia c potential for malignant transformation
Hyperplastic polyp

Hamartomatous / syndromic polyp
Hamartoma = native tissue elements from the bx site forming disorganized polyp
- may be assoc c PJ, juvenile polyposis, or Cowden dz
- although hyperplastic polyps can have more edema, inflamed lamina propria vs PJ polyps, usually not possible to differentiate them based solely on histology
Peutz-Jehger syndrome assoc c mucocutaneous melanin pigmentation and hamartomatous intestinal polyps; assoc c STK11 (serine/ Threonine protein kinase), near complete penetrance
Hamartomatous polyp


Cronkhite-Canada polyp
Lots of gastric hyperplastic polyp-like cystically dilated lesions and more edematous (somewhat similar to juvenile polyposis) in sm / lg bowels
- inc risk of colorectal ca


Cronkhite-Canada polyp, with broad sessile base, expanded edematous lamina propria, and cystic glands
Pancreatic acinar cell metaplasia / heterotopia
Can produce gastric outlet obstruction; lesions may have central umbilication 2/2 mucosal erosion
- may be mistaken for well-diff NE (carcinoid)
- finding pancreatic metaplasia in oxyntic mucosa should lead to considering the dx of AMAG (1/2 are assoc c AMAG)
IHC: does not express NE markers
Pancreatic heterotopia with overlying gastric mucosa

Gastric xanthoma
Small (<3mm) pale yellow nodules in gastric mucosa, usually in groups along lesser curvature and pylorus
- no assoc c hypercholesterolemia; can be misdiagnosed as carcinoma; may be assoc c H pylori
Micro: lipid-laden histiocytes in lamina propria that can extend to submucosa
IHC: (+) CD68, neg keratin
Gastric xanthoma


Intestinal / Gastric foveolar-type adenoma
Japanese didn't use invasion as a criteria to dx carcinoma, resulting in better cure rates for early ca detection, vs West
- if lesion forms polyp, called adenoma (must add grade of dysplasia); if flat called "dysplasia" and graded similar to esophagus
- must sample entire stomach to exclude invasive ca
- gastric adenomas distributed equally throughout stomach, and are usually solitary (4/5) and can have AC (1/10)
- almost always occur in background of chronic gastritis c atrophy and intestinal metaplasia
Although results have varied, can be classified as :
- intestinal-type c at least focal goblet cells +/- Paneth cells, may be more likely to have high-grade dysplasia, ca (AC), c surrounding metaplasia and gastritis; adenomatous dysplasia more likely to be in body/fundus, 2/2 multiple cycles of injury, larger multifocal lesions,
- gastric foveolar type - lined entirely c gastric mucin cells on PAS/Alc Blue, background oxyntic type mucosa normal indicating they arise sporadically more assoc c flat lesions; assoc c FAP syndrome, assoc c AC, can be seen c higher-grade lesions; can have intestinal metaplasia
- indeterminate
Flat dysplasia can be seen c gastric atrophy from H pylori infx or autoimmune gastritis
- LG-dysplasia may not be visible endoscopically
- HG lesions have more severe cytologic atypia and irreg architecture, inlcuding gland budding, gland-within-gland, or cribriforming
Tx: HG-dysplasia may get endoscopic mucosal resection (EMR) or regular surgical resection
Px: LG-dysplasia may regress; HG-lesions more likely progress to AC (7/10)
Pyloric gland adenoma



Pyloric gland adenoma (PGA)
Neoplastic polyp ; not very common, F>M; assoc c AMAG, may have H pylori
- can be found in stomach(esp in the body), g-bladda, duodenum, main panc duct
- may be assoc c dysplasia in FAP pts
Micro: closely packed pyloric type glands c cuboidal to low columnar epithelium c pale to reddish ground glass cytoplasm
- nuclei round w/o nucleoli
- commonly have foci of dysplasia (HG>LG) / ca
IHC: (+) MUC6 (pyloric gland mucin), MUC5AC (foveolar mucin)
- neg MUC2 (intestinal mucin), CDX2
- areas of transition from gastric to intestinal diff can show (+) MUC2 and CD10
Tx: complete excision
Oxyntic gland polyp / adenoma
- Unusual fundic gland polyp variant MC in cardia/corpus; may be referred to as chief cell prolif of gastric mucosa or chief cell hyperplasia c structural and nuclear atypia
Micro: anastomosing cords of irreg branched tubules c monotonous epithelial cells c central round nuclei and amphophilic cytoplasm assoc c oxyntic and foceolar microcysts
- can have nuclear atypia c nuclear stratification suggestive of tubular ca
- mits and Ki67 low
- parietal cells are scattered amongst chief cells
- can be assoc c fundic gland polyp
EM:
Tx: should get endoscopic f/u but no other intervention necessary

Oxyntic gland adenoma

Mesenteric Fibromatosis
wavy spindle cells, no atypia, keloid type collagen deposits, infiltrative borders, prominent muscular arteries and veins
- low mits (no atypical mits)
Zollinger-Ellison syndrome
Gastroma (hypertrophic gastropathy) that causes hypergastrinemia leading to inc acid secretions and severe Peptic Ulcer Disease (PUD)
Gross: very hypertrophied rugae in body and fundus, atrophic antrum
Micro: inc parietal cells, dec foveolar; oxyntic mucosal thickness doubles
Tx: block acid hypersecretion (PPIs)
- should focus on gastrinomas, which grow slowly and majority malig
Adenocarcinoma (AC)
MCC stomach cancer (90-95%), M>F, higher risk in Eastern countries, South America, AMAG also puts at risk; is occurring more in gastric cardia
- Can be divided into intestinal (bulky) and diffuse (more often have signet ring cells) types
Intestinal type AC assoc c H pylori infx
-- Lauren classification found intestinal type-tumors have better survival than diffuse type
Hereditary diffuse gastric carcinoma assoc c mutation in E-cadherin or alteration of its gene expression
- has AD pattern of inheritance
Early aggressive local spread and lymph node/ liver mets
- asymptomatic until late; mets usually found at dx
Assoc w/ nitrosamines (smoked foods), achlorhydria, chronic gastritis (H pylori), type A blood
- gastric adenomas and dysplasia are precursors
Signet ring cells and acanthosis nigricans common features.
Linitis plastica ("leather bottle") may occur when diffusely infiltrative
Tumor may also be: ulcerating, polypoid, or superficial spreading
Virchow node: mets to L. supraclavicular node
Krukenberg's tumor: bilateral mets to ovaries. Abundant mucus, Signet ring cells
Sister Mary Joseph nodule: subcutaneous periumbilical mets
Irish node - enlarged left axillary lymph node
Leser-Trelat syndrome: sudden dermatologic onset of seborrheic keratosis (look for underlying gastric malignancy)
Micro: intestinal type tumors are large masses that form c intestinal metaplasia in background
- diffuse type seem to arise de novo in normal mucosa background, can be sneaky and have signet rings and look like macrophages from lower power
- may appear hepatoid (poor px; +SALL4), clear cell, squamoid, micropapillary
- lymphoepithelial-like AC is lacy and can be EBV+
IHC: (+) HER2 regularly suggested (from ToGA trial; HER2 IHC is superior to FISH), CDX2, CK7, CK20 (while keratins can be helpful, should not be used on all ulcers bc can highlight scurry lookin single cell pattern in regenerative tissue); PAS/AB reveals abnormally colored cells and has strange effect on mucin;
- negative CD44, EBV, E-cadherin (in hereditary AC)
Like breast cancers, ~20% of gastric cancers and 30% of gastroesophageal junction cancers overexpress HER2
- unlike breast cancer Her2 overexpression by either FISH or IHC is evidence of likely response
Labs: inc CEA in 45-50%; CA19-9 in 20%
- may consider HER2 by FISH if IHC is equivocal
Genes: ~1/2 sporadic diffuse are hereditary, assoc c CDH1 gene (encodes E-cadherin); has 7/10 penetrance; esp get signet ring AC and also assoc c lobular ca of the breast
- prophylactic gastrectomy may be offered to CDH1 gene carriers; CDH1 mutations assoc c gastric signet ring ca and lobular carcinoma of the breast
- sporadic intestinal type assoc c Wnt pathway mutations (such ass loss-of-function of APC tumor suppressor gene and gain-of-function of B-catenin
DDx: chemical gastropathy, crushed oxyntic mucosa
Tx: Distal 1/3: subtotal gastrectomy
- proximal 2/3 or infiltrative lesions: Total gastrectomy w/ adjuvant chemo and rads
- trastuzumab in HER2+ cases
Px: depth of invasion and extent of nodal and distant mets are most impartant px factors
- 1/2 of pts die of dz; AC found outside cardia has better px vs gastric cardia AC
- stage assoc c survival (Lauren classification)
AJCC staging Gastric cancer


In situ signet ring cells in gastrectomy for hereditary diffuse gastric cancer, mutation in CDH1

Pitfall -- crushed mucosa with prominent mucus neck cells note the sloughed
single cells are seen in gland lumina oil immersion (bad idea)

Hereditary Diffuse Gastric Cancer (HDGC)
major cause is germline mutations in CDH1, which encodes e-cadherin; thus pts c HDGC at risk for lobular breasst ca and diffuse signet ring cell ca
- prophylactic gastrectomy is the only way to prevent gastric ca in pts c CDH1 mutation
GastroIntestinal Stromal Tumor (GIST)
MC mesenchymal tumor of the abdomen, usually in muscularis propria; vary in px and differentiation according to location in GI
- 60% in stomach, 30% in sm intestine; 1/4 are malig
Peak age is 60 years; 1/2 present c mets
- can be found in 1/3 resected stomachs
- if found in female kiddos, think Carney's triad: GIST, extra-adrenal paraganglioma and pulmonary chondroma
- was thought to be of sm muscle origin, even though no sm muscle was seen on EM
- Arise from cells of Cajal (pacemaker cells)
Micro: usually spindled, but can be epithelioid (and cause confusion)
- spindly tumors have palisading, paranuclear vacuoles, collagen fibrils
1/10 are epithelioid GISTs, 3/4 are b9;
- larger tumors in fundus or cardiac more likely to be malig
- up to 3/5 met, usually w/in 2 yrs; which has 8 mo avg survival
- inc prolif and necrosis may have worse outcomes
- also has worse outcome if it invades into mucosa
Genes: 4/5 have gain-of-function of tyrosine kinase KIT
- CD117 mutation at exon 11 (???)
2 types of KIT mutation groups: regulatory site type (which allows binding of imatinib) and enzymatic site mutation (which prevents binding of imatinib)
-- pts may develop resistance to imatinib
~ 5-10% of GISTs do not have KIT mutations and are assoc c PDGFRA mutations (require different tx)
Succinate dehydrogenase (SDH)-deficient GIST
If the GIST does not have KIT or PDGFRA mutations, consider germline loss of SDH (succinate dehydrogenase complex) assoc c Carney-Stratakis syndrome: GIST and paraganglioma; which is distinct from Carney triad (although SDH-def GISTS also assoc c Carney triad). Both have loss of SDHB expression by IHC
- SDH deficienct GIST is aka "pediatric type GIST" (bc is the MCC GIST in kiddos) and is usually plexiform/multinodular; usually more epithelioid; very rare in pts > 40 yo
- IHC: loss of SDH subunit B (SDHB) expression, but are still CD117 and DOG1+
Grading ***5-5-10-50!!***:
Benign: <5 cm, <5 mits/ 50 hpf
Uncertain malig potential: cellular, <5 cm, >5 mits/ 50 hpf
Low-grade gastric GIST: cellular, >5 cm OR <10 mits
High-grade: cellular, any size, >50 mits
IHC: (+) CD117 (98%), c-kit, DOG1 (Discovered On GISTs), CD34 (7/10), bcl2, actin (3/10)
- rare cases can be CD117 negative (3/4 have PDGFRA mutation, 1/10 have KIT mutation)
- suggested panel: CD117, CD34, SMA, desmin, CK, S100, melanA, DOG1, SDH
Genes: 96% express c-Kit (CD117/34)
- activating mutations in KIT genes (esp exons 11>9>13/17)
- PDGFRA mutations assoc c epithelioid morphology
- some can have BRAF or NF1 mutations
- assoc c NF1 in sm intestines, which is KIT wild type (no mutations) but still is CD117+
Tx: imatinib meslate (inhibitor of speciic tyrosine kinases [targets PDGFr]) effective in metastatic GISTS (also in CML)
- mutation in KIT exon 11 is highly assoc c imatinib response; mutations in exons 9, 13, and 17 are somewhat less likely (40-50%) to be imatinib sensitive; tumors c no KIT mutation may be imatinib sensitive in up to 30% of cases
- the MC PDGFRA mutation (D842V) is completely insensitive to imatinib, while others may be responsive
Px: most important are size, mits and location of primary lesion (stomach best, then small intestestine, then colorectum)
- 1/5 are malig; poorer px if >5 mits/50 hpfs or >5 cm
- 2/5 5-yr survival; surgery not really proven to help

Epithelioid GIST

Spindle-celled GIST
GIST grading

Well-differentiated Neuroendocrine tumors (carcinoid tumors) and other neuroendocrine tumors
Historically known as Carcinoid tumors; they arise from the enterochromaffin-like (ECL) cells throughout the gut
- carcinoid really must have production of serotonin, and cause carcinoid syndrome
- collections of NE cells <0.5 mm known as NeuroEndocrine (NE) cell hyperplasia
- Micro-NE tumors are those 0.5 to 5 mm that are not identified endoscopically
Types:
- classified into several type:
(1) ECL tumors assoc c chronic atrophic gastritis, type A
(2) ECL tumors assoc c ZE syndrome or MEN1 (and hypergastrin secretion from gastrinoma)
(3) sporadic ECL lesions (w/o hypergastrinemia)
(4) Non-ECL tumors
(5) ECL cell tumor c achlorhydria and parietal cell hyperplasia
- autoimmune atrophic gastritis (abs against parietal cells) causes loss of oxyntic glands and mucosal atrophy, causing dec HCl production and hyperproduction of gastrin by antral G cells, causing tumors that can be multifocal
- type 3 (sporadic) lesions are more aggressive, req aggressive surgery
- all have small round proliferating cells
- confirm c NE stains
- graded c mits and Ki67 ([1] = <2 mits/hps or <2% Ki67; [2] = 2-20 mits /hpf or 3-20% Ki67; [3] = HG NE Ca c >20 mits/hpf or Ki67>20%)
- pt gets chemotx if Ki67 >20%
- carcinoid in foregut (stomach and prox duodenum) rarely met and cured c resection
- midgut carcinoids more aggressive
1) Well-differentiated NeuroEndocrine Tumors (WDNETs)
- aka NeuroEndocrine Tumors Grade 1 (NET G1)
MCC, originate from ECL cells
- even well-diff lesions can invade vessels
Tx: If not HG, can be remove endoscopically; possibly somatostatin analogues
Px: Well-differentiated, those that make gastrin have good px and usually don't met, though can met to liver
2) Assoc c ZE syndrome (gastrin-secreting neoplasm, usually in pancreas) and MEN-I; causing hyperplasia of intract parietal cells
IHC: negative gastrin (bc made of ECL cells)
Tx: Regresses c tx of underlying gastrinoma
3) Sporadic, poorly differentiated; may have intact mucosa above tumor if sporadic
Tx: Must treat as gastric carcinoma, with chemotx
Px: most important px factor is location
- worse if >2 cm
Small cell ca can have (+) CD117 and absent KIT mutations


Gastric carcinoid tumors / appendix[?]
Well-diff NE tumor
Carcinoid with nesting, rosetting, and pseudoalveolar forms


Gastric MALT lymphoma
LG B-cell lymphoma of Mucosa-Assoc Lymphoid Tissue (MALT); may be called extranodal marginal zone lymphoma
90% assoc c H pylori
30% plasmacytic differentiation
Micro: at low power, lamina propria expanded c small uniform cells, some of which have a "halo" around
- should start to assess muscularis mucosae, which usually have infiltrates of cancer cells
- the "lymphoepithelial" lesion (LEL) has lymphs scattered in residual gland epithelium (but not always there)
IHC: (+) CD20/79a, BCL2, IgM, can have plasmacytoid differentiation c Ig LC restriction; should assess for H pylori
- variable CD11c/43
- neg CD5/10/23
may assess for CD20 reactive B cells that aberrantly express CD43; should also compare cells that may coexpress CD3 and CD43 (which is normal)
Genes: all translocations 2/2 pathway assoc c nuclear factor kappaLC enhancer of activated B cells (NFkB)
t(11:18)(q21;q21), API2/MALT1 in up to 1/3; not assoc c H pylori infx (thus do not respond to abc tx); but does have nuclear BCL10 expression
- also t(1;14)(p22;q32) IGH-BCL10, t(14;18)(q32;q21) IGH-MALT1; and t(3;14)(p14;q32) IGH-FOXP1
-- note the q32 located on the cr14; q21 for cr18
DDx: lots of plasma cells usually seen in reactive lesions (H pylori gastritis)
- other large B cell gastric lymphomas c large-cell rich infiltrat, should run flow, stain for CD117 / c-kit, CD20/3, and keratins, and S100, CD30
Tx: 50% will not improve c treatment of underlying H pylori
- posttreatment histo grading system based on eval of lymphoid infiltrate, LEL presence, and stromal changes
can grade as "Complete Histological Response (CR)", "Probable minimal residual dz (pMRD)", "Responding Residual Dz (r-RD)" and "No Change (NC)"
- rRD implies lymphoma is present, but also has features to suggest that it is responding, which means to stay on current tx
Px: can induce long-term remission in 4/5 cases
- LG lymphomas can infrequently appear c tx of H pylori, but they spontaneously regress

Gastric MALT lymphoma

Lymphoepithelial lesion

Granular cell tumor of stomach
Very rare compared to occurance in esophagus (also rare), sometimes seen
- usually b9
Can have pseudoepitheliomatous hyperplasia on top of them which can look like SCC!!
- can tell the difference bc pseudoepitheliomatous hyperplasia will still have bridging between the cells
Granular cell tumor with striking pseudoepitheliomatous hyperplasia which can look like invasive SCC (but its not!!!) [1]

Neural tumors
not usually seen in gastric bx, most gastric nerve sheath tumors classified as schwannoma, though can have pt c syndromic nerve sheath tumors (NF, neuroma, ganglioneuromas)
Schwannoma
Usually involve both lamina propria and submucosa; rarely seen in esophagus or colon
- 4F>1M; grossly similar to GIST (rubbery, firm, white-yellow cut surface, well-circumscribed but non-encapsulated (vs in PNS)
- 9/10 surrounded by lymphatic cuff and have GCs, and have diffuse intralesional lymphs
- can sometimes have ulceration
Micro: have interlacing bundles of spindle cells that can be weakly palisaded tho verocay bodies rare (vs GISTs which have prominent palisading); often with discontinuous cuff of lymphoid tissue
- can have myxoid change, xanthoma cells or vascular hyalinization
- mits low;
IHC: S100 (strong), var GFAP (1/4 to all are +)
- neg muscle markers and CD117; CD34 (rarely +)
Genes: do not have KIT or PDGFRA mutations
- Rarely has NF1/2 genetic mutations (multiple Cr 22, 2, 18) which are common is soft tissue schwannomas
Px: B9
- the reticular and microcystic versions have predilection to the viscera
Gastric Schwannoma

Glomus tumors
B9; Usually in distal extremities, but can be deep in gastric muscularis propria; rare in GI; F>M, 6th decade; can cause melena c upper Gi pain
- made of smooth muscle cells on EM
Micro: solid sheets of uniform cells surrounding gaping capillary vessels in HPC-like pattern
- nodules separated by strands of residual muscularis propria c ulceration of mucosa over lesion
- tumor cells round c sharply defined cell membranes, round nuclei and delicate chromatin; can have bright red cytoplasm
- can have mits (usually <5 per 50 hpf's) or mild atypia
- has a background network of collagen type 4 and laminin
IHC: (+) SMA, calponin, h-caldeson
- neg desmin, CD117/c-kit, S100, CHR, CD34, melanA
- pericellular reticular pattern c BM proteins (laminin and collagen IV), may have focal CD34
DDx: carcinoids (neuroendocrine tumors) and GISTs
Glomus tumor

Perineurioma
Can have processes that look like sperm
Perineurioma

Perineurioma - sperm-like processes [1]

Synovial sarcoma
rare in GI; but stomach MC usually in young adults as polyps or submucosal plaques, tho can be transmural
IHC: (+) keratins, EMA, BCL2, sometimes CD99
- neg CD45, kit, DOG1
Genes: SYT-SSX1/2 gene fusion
Plexiform fibromyxoma
specific to stomach, in antrum, no gender or age predominance
- plexiform growth c rich vascularized paucicellular nodules of spindle cells c minimal mits
(+) SMA and CD10, neg DOG1
Gastroblastoma
Very rare, can be in muscularis propria, but overlaps c NE tumors
- peculiar biphasic (epithelial and mesenchymal) cancers in kiddos and young adults
- called gastroblastoma bc share features c other blastomas in kiddos like pleuropulmonaary blastoma and nephroblastoma
- mesenchymal part made of spindle to ovoid cekks w/o structural diff or nuclear atypia; epithelial component overlaps c NE tumors, but occupies less than mesenchymal part but does not express NE markers!
Micro: epithelial part forms clusters that blend c mesenchymal cells and form luminal structures in inspissated eosinophilic secretions
- no atypia
IHC: (+) keratins (epithelial part), CD10 and vimentin in mesenchymal part
Genes: MALAD1-GLI fusion
Gastroblastoma with epithelioid and spindle areas

Gastroblastoma, keratin stain, epithelioid cells positive, spindle cells negative

Metastasis
usually lobular breast ca, RCC, melanoma, HCC
References
1. LASOP meeting, Jan 2022
